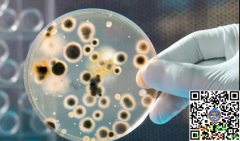

[媒体发稿] 瘢痕医生刘加勇给大家的4点忠告 日期:2018-11-26 12:56:56 点击:166 好评:0
[媒体发稿] 瘢痕医生刘加勇给大家的4点忠告 日期:2018-11-26 12:56:56 点击:166 好评:0
疤痕往往给患者带来心理和生理的双重打击。从表面来看,大部分疤痕患者就医的目的单纯是为了消除疤痕,恢复容貌,让自己更美。然而有一定数量的患者在消除疤痕恢复容貌的目的之下潜藏着更深层的动机。 最常见的例子,比如因为容貌上的缺陷升学和就业遇到困难,受...
 [媒体发稿] 北京疤康做好“加减法” 持续为瘢痕治疗贡献力量 日期:2018-11-26 12:47:37 点击:168 好评:0
[媒体发稿] 北京疤康做好“加减法” 持续为瘢痕治疗贡献力量 日期:2018-11-26 12:47:37 点击:168 好评:0
在中国,每年约有2600万人发生不同程度的烧烫伤,其中儿童群体占到30%以上的比例。在这些烧烫伤儿童群体中,约有48%会遗留瘢痕,8%会导致终身残疾。在2018湖南省整形与美容学术年会暨护理咨询分会上,北京疤康医院孙便友主任明确指出了目前我国烧烫伤群体,尤其是...
 [媒体发稿] 泸州东大肛肠医院口碑如何 为患者健康保驾护航 日期:2018-11-26 12:45:02 点击:68 好评:0
[媒体发稿] 泸州东大肛肠医院口碑如何 为患者健康保驾护航 日期:2018-11-26 12:45:02 点击:68 好评:0
内痔的最佳治疗方法是什么呢?好多患者反映,自己患上了内痔,吃药好久了,都没什么效果,想问下到底要怎么治疗,下面我们一起来看看泸州东大肛肠医院专家关于这个问题的介绍吧。 内痔不治疗会有哪些危害呢? 1、便血、滴血、以及严重的喷血都将导致缺铁性贫血...
[媒体发稿] 对话肿瘤大师――原医科院院长・北京欧亚肿瘤医院专家刘伯齐教授 日期:2018-11-24 14:09:27 点击:122 好评:0
[媒体发稿] 对话肿瘤大师――原医科院院长・北京欧亚肿瘤医院专家刘伯齐教授 日期:2018-11-24 14:09:27 点击:122 好评:0
对于癌症来说,我们每一个人迟早都会有一次或者多次近距离接触。 癌症不仅仅是一种疾病,而是许多种疾病所组成的,统统称为癌症,是因为它们都有一个共同的基本特征细胞的异常增长。 癌症这种从古埃及的文献和木乃伊中就存在的疾病,看上去好像是永生的,如何寻找...
 [媒体发稿] 中华预防医学会精神卫生分会2018年学术年会召开,聚焦康黎精准医 日期:2018-11-23 16:05:07 点击:148 好评:0
[媒体发稿] 中华预防医学会精神卫生分会2018年学术年会召开,聚焦康黎精准医 日期:2018-11-23 16:05:07 点击:148 好评:0
上海康黎医学检验所致力于将药物基因组学和代谢组学技术应用于精神类疾病治疗临床实践,并建立针对中国人群的精神疾病用药相关基因变异位点临床数据库,该数据库研究价值极高,有利于推动精准用药在我国精神疾病领域的发展和应用。 健康中国 美好生活 中华预...
 [媒体发稿] 北京中山医院可信不 大肠癌到底会不会遗传 日期:2018-11-23 16:02:45 点击:168 好评:0
[媒体发稿] 北京中山医院可信不 大肠癌到底会不会遗传 日期:2018-11-23 16:02:45 点击:168 好评:0
大肠癌患者和家属非常关心的一个问题是,大肠癌有没有传染性?有没有遗传性?尤其是一些家中有小孩的家长,非常担心把疾病传染或遗传给孩子们。 其实,大肠癌是一种与基因变异有关的疾病,肯定没有传染性,所以即使老人患上了大肠癌也没有必要与家人隔离,依然可以与...
 [媒体发稿] 体外碎石7次无效!终于找到救命稻草-济南肾病医院 日期:2018-11-23 16:01:15 点击:136 好评:0
[媒体发稿] 体外碎石7次无效!终于找到救命稻草-济南肾病医院 日期:2018-11-23 16:01:15 点击:136 好评:0
患者刘明,今年49岁,家住山东滨州市。上班工作时,突然腰部疼痛的厉害,于是就去了滨州当地医院去检查,结果确是那么出人意料 肾结石 。听到这样的的诊断结果,刘明来不及问清病因,就匆忙的准备做碎石手术。 我在滨州等医院先后做了7次碎石 ,这七次碎石下来,钱花...
 [媒体发稿] 用整套菌菇疗法治癌应当坚决,不能三心二意 日期:2018-11-23 15:59:08 点击:149 好评:0
[媒体发稿] 用整套菌菇疗法治癌应当坚决,不能三心二意 日期:2018-11-23 15:59:08 点击:149 好评:0
2018年9月17-22日,德国药用菌菇研究所创始人,世界著名药用菌菇专家弗兰茨.施茂斯先生对中国进行了一次成功的讲学、考察访问。访问期间,他参观了绿芸公司及其自然疗法诊所,与癌症患者们进行了一对一的交流,并对中国的自然疗法师做了培训。 通过与施茂斯先生的...
 [媒体发稿] GISE广州睡博会――2019再度启航 招展正式启动 日期:2018-11-23 10:59:19 点击:117 好评:0
[媒体发稿] GISE广州睡博会――2019再度启航 招展正式启动 日期:2018-11-23 10:59:19 点击:117 好评:0
党的十九大报告中提出实施健康中国战略。睡眠产业作为大健康产业中重要的组成部分,蕴含着宏观政策、技术进步、市场融合等诸多机遇。随着一带一路战略的实施,中国睡眠企业不仅需要国内布局,更需要全球视野。以关注健康睡眠,引领健康未来为主题的第二届中国...
 [媒体发稿] 优瓦科技重金备货欧洲药典标准品(EP)|客户下单3-5天可收货 日期:2018-11-22 11:21:17 点击:58 好评:0
[媒体发稿] 优瓦科技重金备货欧洲药典标准品(EP)|客户下单3-5天可收货 日期:2018-11-22 11:21:17 点击:58 好评:0
《欧洲药典》作为欧洲药品质量检测的唯一指导文献,所有药品和药用底物在欧洲范围内推销和使用的过程中,必须符合《欧洲药典》的质量标准。因此,一般要出口到欧洲的药物其生产和检测所需药品及相关对照品、标准品都必须使用到EP标准的产品。 但在标准品行业中,...